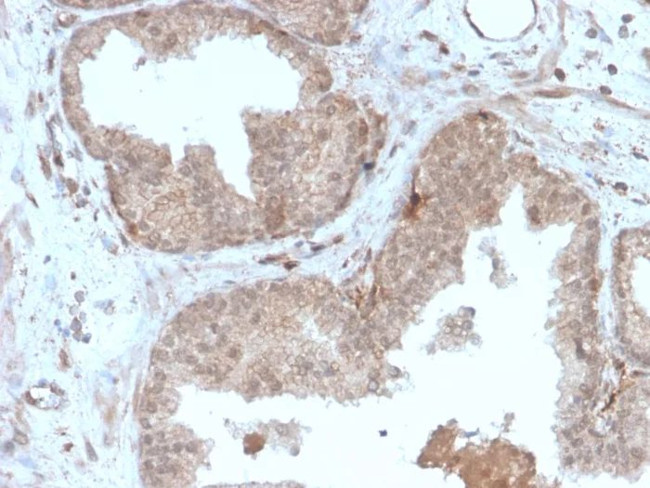
Major Vault Protein (MVP) Antibody in Immunohistochemistry (Paraffin) (IHC (P))

Search
NeoBiotechnologies
Major Vault Protein (MVP) Recombinant Mouse Monoclonal Antibody (r1032)
{{$productOrderCtrl.translations['antibody.pdp.commerceCard.promotion.promotions']}}
{{$productOrderCtrl.translations['antibody.pdp.commerceCard.promotion.viewpromo']}}
{{$productOrderCtrl.translations['antibody.pdp.commerceCard.promotion.promocode']}}: {{promo.promoCode}} {{promo.promoTitle}} {{promo.promoDescription}}. {{$productOrderCtrl.translations['antibody.pdp.commerceCard.promotion.learnmore']}}
产品信息
9961-MSM4-P1
种属反应
宿主/亚型
Expression System
分类
类型
克隆号
抗原
偶联物
形式
浓度
规格
纯化类型
保存液
内含物
保存条件
运输条件
产品详细信息
Positive Control:MCF-7 or HeLa cells. Human breast tumors.
Cellular Location: Cytoplasm.
靶标信息
This gene encodes the major vault protein which is a lung resistance-related protein. Vaults are multi-subunit structures that may be involved in nucleo-cytoplasmic transport. This protein mediates drug resistance, perhaps via a transport process. It is widely distributed in normal tissues, and overexpressed in multidrug-resistant cancer cells. The protein overexpression is a potentially useful marker of clinical drug resistance. This gene produces two transcripts by using two alternative exon 2 sequences; however, the open reading frames are the same in both transcripts.
仅用于科研。不用于诊断过程。未经明确授权不得转售。
篇参考文献 (0)
生物信息学
蛋白别名: lrp; Lung resistance-related protein; Major vault protein; MVP; MVP1; Testicular Secretory Protein Li 30; unnamed protein product; VAULT1; vRNP
基因别名: LRP; MVP; VAULT1
UniProt ID: (Human) Q14764
Entrez Gene ID: (Human) 9961